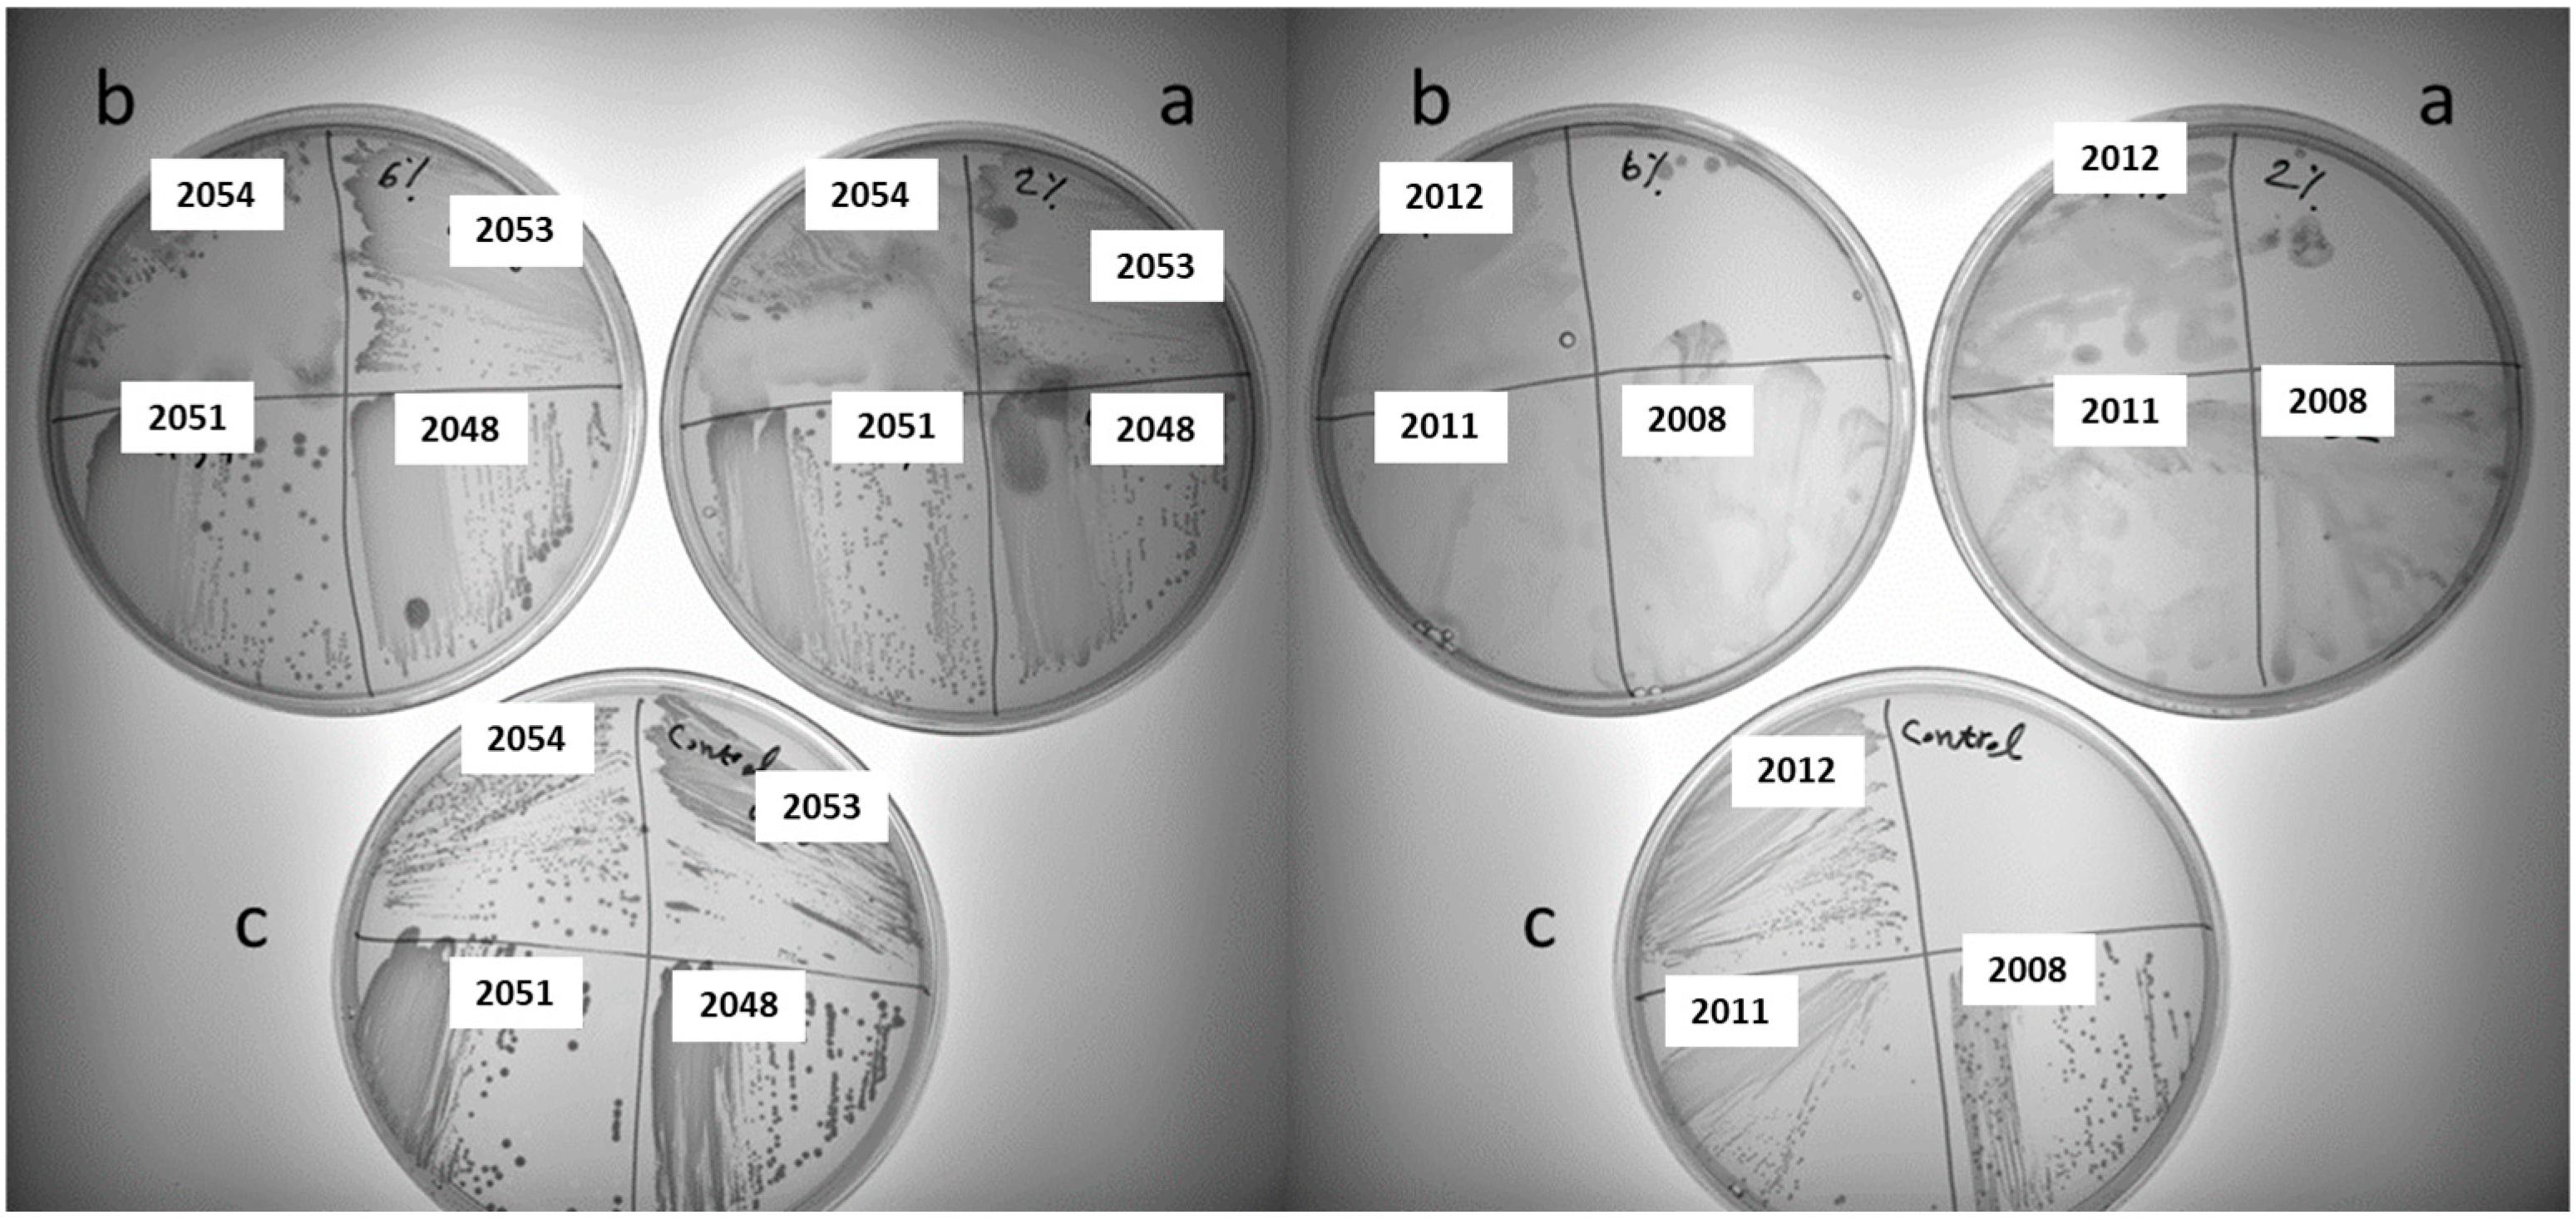
Foods 13 02907 g002
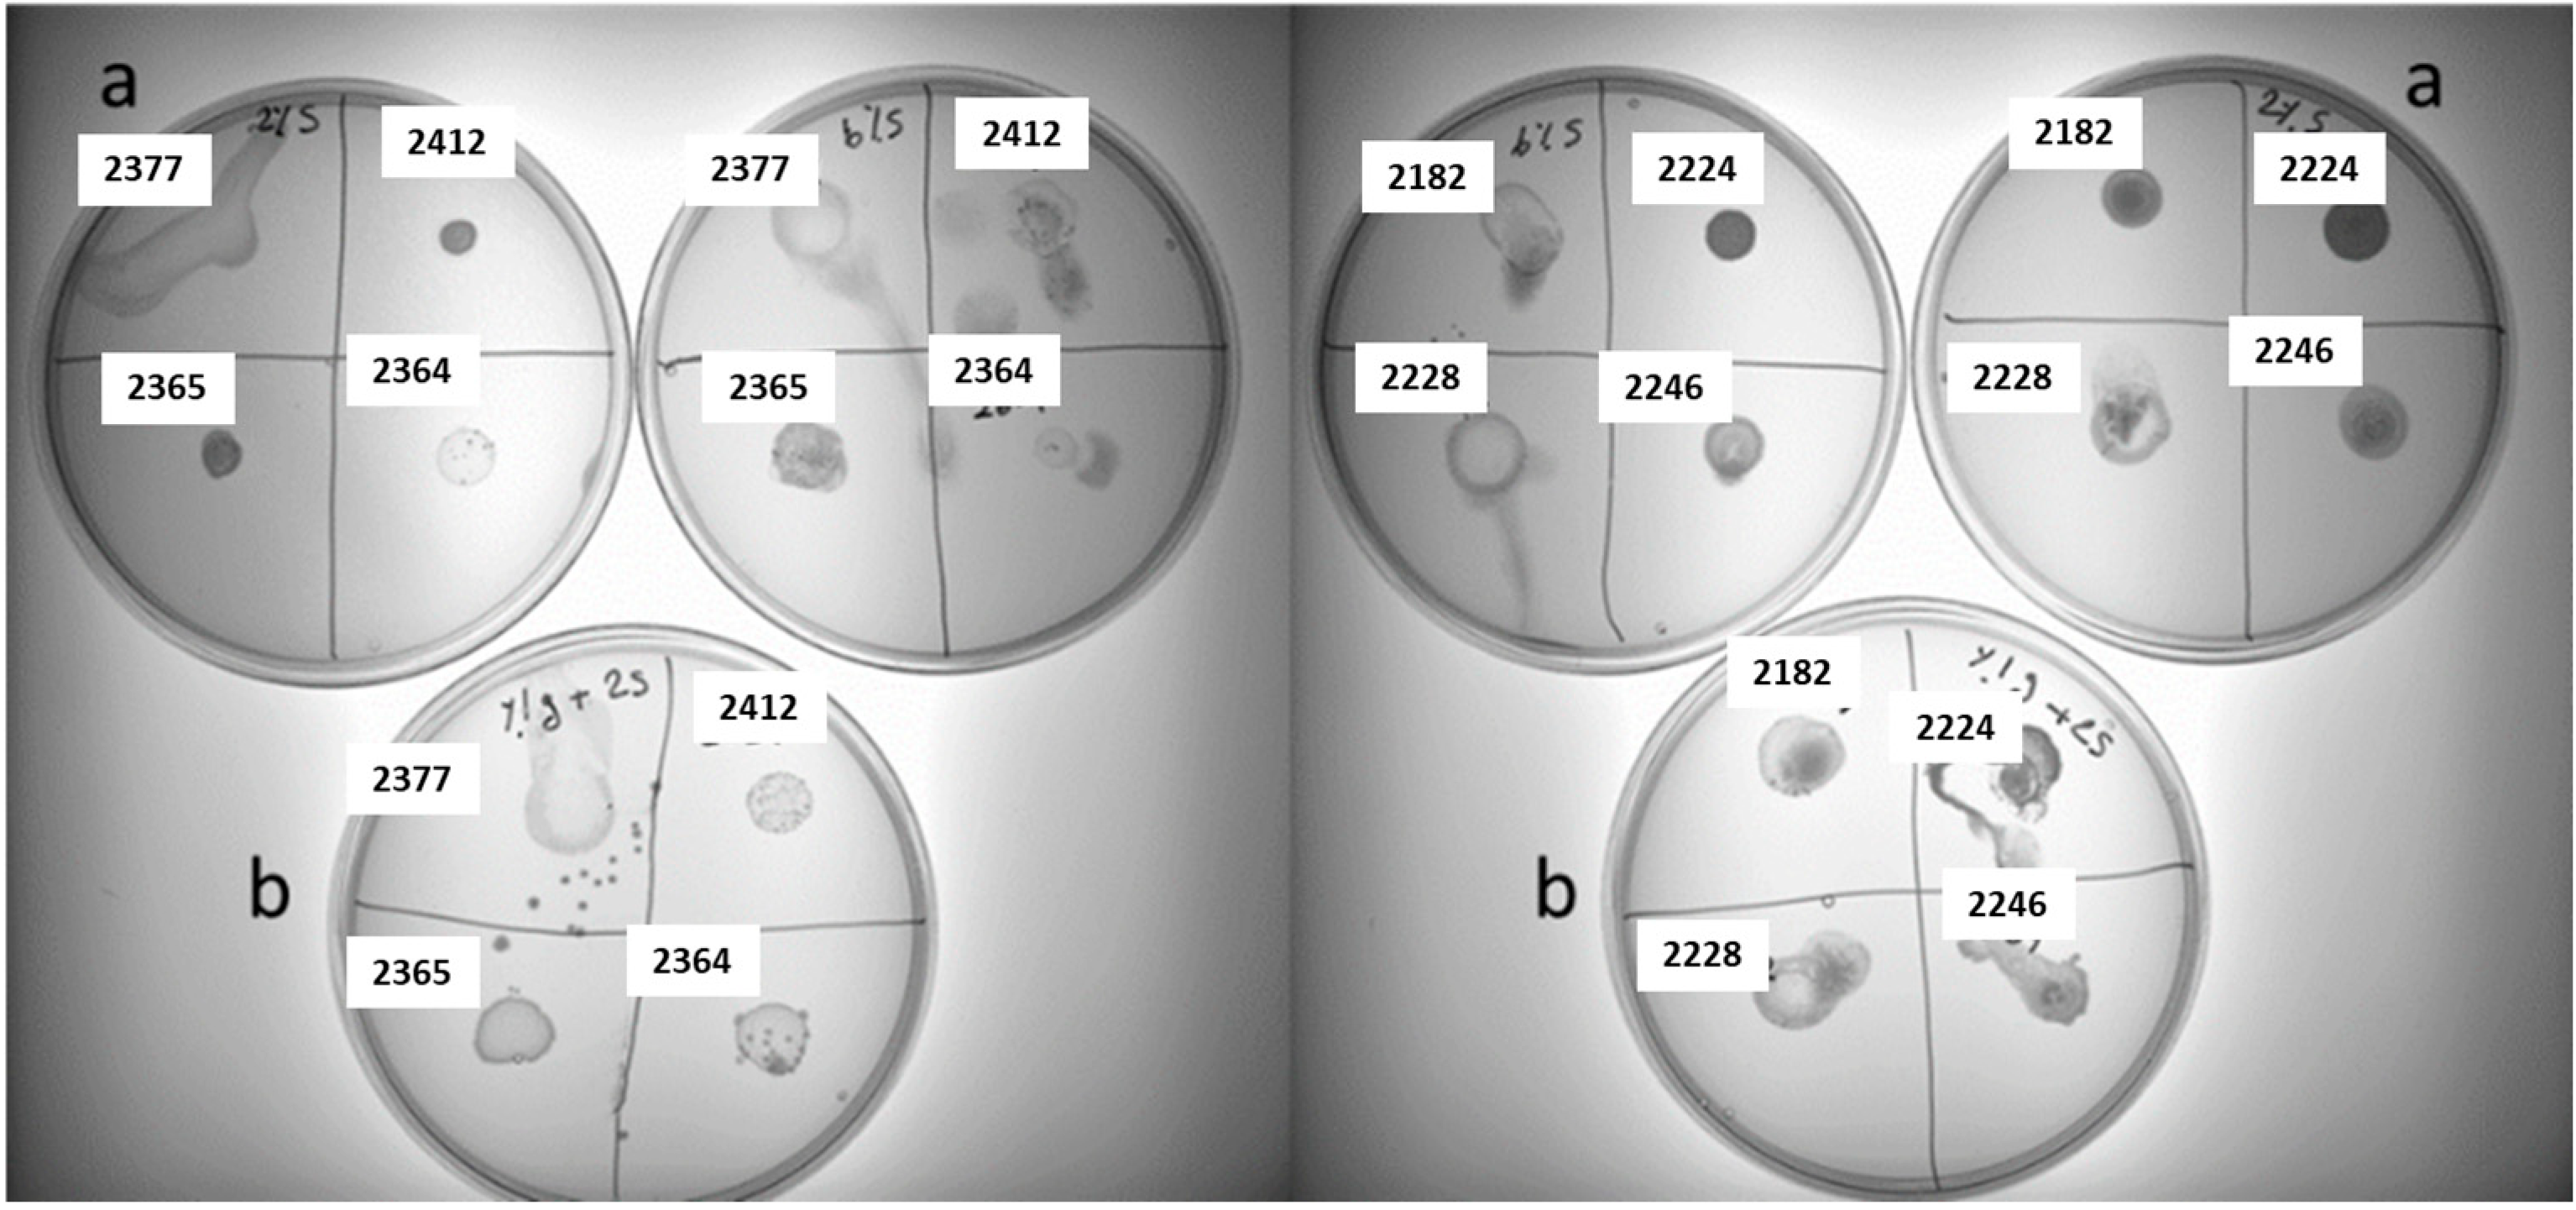
Foods 13 02907 g003

Exploring the Diversity and Potential Use of Flower-Derived Lactic Acid Bacteria in Plant-Based Fermentation: Insights into Exo-Cellular Polysaccharide Production
Abstract
1. Introduction
2. Materials and Methods
2.1. Preparation of Flowers
2.2. Screening and Isolation of LAB Strain from Flowers
2.3. Identification of Isolated LAB Strains from Flowers Using MALDI-TOF, PCR, and De-Replication
2.4. Screening for Exo-Cellular Polysaccharide Producers
2.5. Isolation and Purification of Exo-Cellular Polysaccharides
2.6. Determination of Monosaccharides by High-Performance Liquid Chromatography (HPLC) Analysis
2.7. High-Throughput Screening for Texturing Strains in Plant-Based Drink
3. Results and Discussion
3.1. Diversity of Plant-Based LAB Strains According to MALDI-TOF, PCR, and De-Replication
3.2. Screening for Polysaccharide-Producing LAB Strains on Different Sucrose-Supplemented Media
3.3. Determination of Monosaccharide Composition by HPLC Analysis
3.4. High-Throughput Screening for Texturing Strains
4. Conclusions
Supplementary Materials
Author Contributions
Funding
Institutional Review Board Statement
Informed Consent Statement
Data Availability Statement
Acknowledgments
Conflicts of Interest
References
- Yang, X.; Hong, J.; Wang, L.; Cai, C.; Mo, H.; Wang, J.; Fang, X.; Liao, Z. Effect of Lactic Acid Bacteria Fermentation on Plant-Based Products. Fermentation 2024, 10, 48. [Google Scholar] [CrossRef]
- Wang, Y.; Tuccillo, F.; Lampi, A.M.; Knaapila, A.; Pulkkinen, M.; Kariluoto, S.; Coda, R.; Edelmann, M.; Jouppila, K.; Sandell, M. Flavor challenges in extruded plant-based meat alternatives: A review. Compr. Rev. Food Sci. Food Saf. 2022, 21, 2898–2929. [Google Scholar] [CrossRef] [PubMed]
- Montemurro, M.; Pontonio, E.; Coda, R.; Rizzello, C.G. Plant-based alternatives to yogurt: State-of-the-art and perspectives of new biotechnological challenges. Foods 2021, 10, 316. [Google Scholar] [CrossRef] [PubMed]
- Pua, A.; Tang, V.C.Y.; Goh, R.M.V.; Sun, J.; Lassabliere, B.; Liu, S.Q. Ingredients, processing, and fermentation: Addressing the organoleptic boundaries of plant-based dairy analogues. Foods 2022, 11, 875. [Google Scholar] [CrossRef]
- Endo, A.; Maeno, S.; Tanizawa, Y.; Kneifel, W.; Arita, M.; Dicks, L.; Salminen, S. Fructophilic lactic acid bacteria, a unique group of fructose-fermenting microbes. Appl. Environ. Microbiol. 2018, 84, e01290-18. [Google Scholar] [CrossRef]
- Huang, W.; Dong, A.; Pham, H.T.; Zhou, C.; Huo, Z.; Wätjen, A.P.; Prakash, S.; Bang-Berthelsen, C.H.; Turner, M.S. Evaluation of the fermentation potential of lactic acid bacteria isolated from herbs, fruits and vegetables as starter cultures in nut-based milk alternatives. Food Microbiol. 2023, 112, 104243. [Google Scholar] [CrossRef]
- Wu, J.; Han, X.; Ye, M.; Li, Y.; Wang, X.; Zhong, Q. Exopolysaccharides synthesized by lactic acid bacteria: Biosynthesis pathway, structure-function relationship, structural modification and applicability. Crit. Rev. Food Sci. Nutr. 2023, 63, 7043–7064. [Google Scholar] [CrossRef]
- Özpınar, F.B.; İspirli, H.; Kayacan, S.; Korkmaz, K.; Dere, S.; Sagdic, O.; Alkay, Z.; Tunçil, Y.E.; Ayyash, M.; Dertli, E. Physicochemical and structural characterisation of a branched dextran type exopolysaccharide (EPS) from Weissella confusa S6 isolated from fermented sausage (Sucuk). Int. J. Biol. Macromol. 2024, 264, 130507. [Google Scholar] [CrossRef]
- Li, C.; Li, W.; Chen, X.; Feng, M.; Rui, X.; Jiang, M.; Dong, M. Microbiological, physicochemical and rheological properties of fermented soymilk produced with exopolysaccharide (EPS) producing lactic acid bacteria strains. LWT-Food Sci. Technol. 2014, 57, 477–485. [Google Scholar] [CrossRef]
- Yalmanci, D.; İspirli, H.; Dertli, E. Identification of Lactic Acid Bacteria (LAB) from pre-fermented liquids of selected cereals and legumes and characterization of their exopolysaccharides (EPS). Food Biosci. 2022, 50, 102014. [Google Scholar] [CrossRef]
- Poulsen, V.K.; Koza, A.; Al-Nakeeb, K.; Oeregaard, G. Screening for texturing Leuconostoc and genomics behind polysaccharide production. FEMS Microbiol. Lett. 2020, 367, fnaa179. [Google Scholar] [CrossRef] [PubMed]
- Zeidan, A.A.; Poulsen, V.K.; Janzen, T.; Buldo, P.; Derkx, P.M.; Øregaard, G.; Neves, A.R. Polysaccharide production by lactic acid bacteria: From genes to industrial applications. FEMS Microbiol. Rev. 2017, 41 (Suppl. S1), S168–S200. [Google Scholar] [CrossRef] [PubMed]
- Daba, G.M.; Elnahas, M.O.; Elkhateeb, W.A. Contributions of exopolysaccharides from lactic acid bacteria as biotechnological tools in food, pharmaceutical, and medical applications. Int. J. Biol. Macromol. 2021, 173, 79–89. [Google Scholar] [CrossRef] [PubMed]
- Jurášková, D.; Ribeiro, S.C.; Silva, C.C. Exopolysaccharides produced by lactic acid bacteria: From biosynthesis to health-promoting properties. Foods 2022, 11, 156. [Google Scholar] [CrossRef]
- Lynch, K.M.; Coffey, A.; Arendt, E.K. Exopolysaccharide producing lactic acid bacteria: Their techno-functional role and potential application in gluten-free bread products. Food Res. Int. 2018, 110, 52–61. [Google Scholar] [CrossRef]
- Schmid, J.; Sieber, V.; Rehm, B. Bacterial exopolysaccharides: Biosynthesis pathways and engineering strategies. Front. Microbiol. 2015, 6, 496. [Google Scholar] [CrossRef]
- Kavitake, D.; Devi, P.B.; Shetty, P.H. Overview of exopolysaccharides produced by Weissella genus—A review. Int. J. Biol. Macromol. 2020, 164, 2964–2973. [Google Scholar] [CrossRef]
- Xiao, H.; Molina, G.E.S.; Tovar, M.; Quoc, H.M.; Hansen, E.B.; Bang-Berthelsen, C.H. Isolation and characterization of plant-based lactic acid bacteria from spontaneously fermented foods using a new modified medium. LWT 2023, 192, 115695. [Google Scholar] [CrossRef]
- Molina, G.E.S.; Shetty, R.; Xiao, H.; Wätjen, A.P.; Tovar, M.; Bang-Berthelsen, C.H. Development of a novel lactic acid bacteria starter culture approach: From insect microbiome to plant-based fermentations. LWT 2022, 167, 113797. [Google Scholar] [CrossRef]
- Iosca, G.; De Vero, L.; Di Rocco, G.; Perrone, G.; Gullo, M.; Pulvirenti, A. Anti-spoilage activity and exopolysaccharides production by selected lactic acid bacteria. Foods 2022, 11, 1914. [Google Scholar] [CrossRef]
- Poulsen, V.K.; Derkx, P.; Oregaard, G. High-throughput screening for texturing Lactococcus strains. FEMS Microbiol. Lett. 2019, 366, fnz001. [Google Scholar] [CrossRef] [PubMed]
- Ruiz Rodríguez, L.G.; Mohamed, F.; Bleckwedel, J.; Medina, R.; De Vuyst, L.; Hebert, E.M.; Mozzi, F. Diversity and functional properties of lactic acid bacteria isolated from wild fruits and flowers present in Northern Argentina. Front. Microbiol. 2019, 10, 452267. [Google Scholar] [CrossRef] [PubMed]
- Saleh, G. Isolation and characterization of unique fructophilic Lactic acid bacteria from different flower sources. Iraqi J. Agric. Sci. 2020, 51, 508–518. [Google Scholar] [CrossRef]
- Anacarso, I.; Bassoli, L.; Sabia, C.; Iseppi, R.; Condò, C. Isolation and identification of lactic acid bacteria from plants and other vegetable matrices and microbial recombination with Enterococcus spp. Am. Res. Thoughts 2015, 1, 1503–1515. [Google Scholar] [CrossRef]
- Terzić-Vidojević, A.; Veljović, K.; Tolinački, M.; Živković, M.; Lukić, J.; Lozo, J.; Fira, Đ.; Jovčić, B.; Strahinić, I.; Begović, J. Diversity of non-starter lactic acid bacteria in autochthonous dairy products from Western Balkan Countries-technological and probiotic properties. Food Res. Int. 2020, 136, 109494. [Google Scholar] [CrossRef]
- Iorizzo, M.; Pannella, G.; Lombardi, S.J.; Ganassi, S.; Testa, B.; Succi, M.; Sorrentino, E.; Petrarca, S.; De Cristofaro, A.; Coppola, R. Inter-and intra-species diversity of lactic acid bacteria in Apis mellifera ligustica colonies. Microorganisms 2020, 8, 1578. [Google Scholar] [CrossRef]
- Aleklett, K.; Hart, M.; Shade, A. The microbial ecology of flowers: An emerging frontier in phyllosphere research. Botany 2014, 92, 253–266. [Google Scholar] [CrossRef]
- Pimentel, T.C.; de Oliveira, L.I.G.; Macedo, E.d.L.C.; Costa, G.N.; Dias, D.R.; Schwan, R.F.; Magnani, M. Understanding the potential of fruits, flowers, and ethnic beverages as valuable sources of techno-functional and probiotics strains: Current scenario and main challenges. Trends Food Sci. Technol. 2021, 114, 25–59. [Google Scholar] [CrossRef]
- Ruas-Madiedo, P.; Salazar, N.; de los Reyes-Gavilán, C.G. Exopolysaccharides produced by lactic acid bacteria in food and probiotic applications. In Microbial Glycobiology; Elsevier: Amsterdam, The Netherlands, 2010; pp. 885–902. [Google Scholar]
- Fuso, A.; Bancalari, E.; Castellone, V.; Caligiani, A.; Gatti, M.; Bottari, B. Feeding lactic acid bacteria with different sugars: Effect on exopolysaccharides (EPS) production and their molecular characteristics. Foods 2023, 12, 215. [Google Scholar] [CrossRef]
- Paulo, E.M.; Vasconcelos, M.P.; Oliveira, I.S.; de Jesus Affe, H.M.; Nascimento, R.; de Melo, I.S.; de Abreu Roque, M.R.; de Assis, S.A. Método alternativo de triagem de bactérias láticas produtoras de exopolissacarídeos com confirmação rápida. Food Sci. Technol. 2012, 32, 710–714. [Google Scholar] [CrossRef]
- Subramanian, S.B.; Yan, S.; Tyagi, R.D.; Surampalli, R. Extracellular polymeric substances (EPS) producing bacterial strains of municipal wastewater sludge: Isolation, molecular identification, EPS characterization and performance for sludge settling and dewatering. Water Res. 2010, 44, 2253–2266. [Google Scholar] [CrossRef] [PubMed]
- van Hijum, S.A.; Kralj, S.; Ozimek, L.K.; Dijkhuizen, L.; van Geel-Schutten, I.G. Structure-function relationships of glucansucrase and fructansucrase enzymes from lactic acid bacteria. Microbiol. Mol. Biol. Rev. 2006, 70, 157–176. [Google Scholar] [CrossRef] [PubMed]
- Görke, B.; Stülke, J. Carbon catabolite repression in bacteria: Many ways to make the most out of nutrients. Nat. Rev. Microbiol. 2008, 6, 613–624. [Google Scholar] [CrossRef] [PubMed]
- Korcz, E.; Varga, L. Exopolysaccharides from lactic acid bacteria: Techno-functional application in the food industry. Trends Food Sci. Technol. 2021, 110, 375–384. [Google Scholar] [CrossRef]
- Poulsen, V.K.; Moghadam, E.G.; Kračun, S.K.; Svendsen, B.A.; Nielsen, W.M.; Oregaard, G.; Krarup, A. Versatile Lactococcus lactis strains improve texture in both fermented milk and soybean matrices. FEMS Microbiol. Lett. 2022, 369, fnac117. [Google Scholar] [CrossRef]
- Erkus, O.; De Jager, V.C.; Spus, M.; van Alen-Boerrigter, I.J.; Van Rijswijck, I.M.; Hazelwood, L.; Janssen, P.W.; Van Hijum, S.A.; Kleerebezem, M.; Smid, E.J. Multifactorial diversity sustains microbial community stability. ISME J. 2013, 7, 2126–2136. [Google Scholar] [CrossRef]

| Oat, Isola Bio | Almond, Ecomil | Soy, Naturli | |
|---|---|---|---|
| Energy | 215 kJ/51 kcal | 134.00 kJ/32.00 kcal | 153 kJ/37 kcal |
| Fat | 1.0 g | 2.10 g | 2.1 g |
| Carbohydrate | 9.0 g | 3.30 g | 0.6 g |
| -Here sugar | 4.2 g | <0.30 g | 0.6 g |
| Protein | 1.0 g | 1.00 g | 3.7 g |
| Salt | 0.08 g | 0.14 g | 0.09 g |
| No. | Species | NFICC ID | City | Flower |
|---|---|---|---|---|
| 1 | Apilactobacillus kunkeei | 2373 | Odense | Verbascum |
| 2 | Apilactobacillus kunkeei | 2324 | Copenhagen | Rosa |
| 3 | Apilactobacillus kunkeei | 2359 | Aarhus | Fallopia |
| 4 | Apilactobacillus kunkeei | 2362 | Silkeborg | Rubus |
| 5 | Apilactobacillus ozensis | 2370 | Odense | Potentilla |
| 6 | Apilactobacillus ozensis | 2374 | Odense | Jacobaea |
| 7 | Apilactobacillus ozensis | 2363 | Silkeborg | Rubus |
| 8 | Apilactobacillus ozensis | 2366 | Silkeborg | Lavandula |
| 9 | Apilactobacillus ozensis | 2368 | Odense | Jacobaea |
| 10 | Apilactobacillus sp. | 2412 | Silkeborg | Lavandula |
| 11 | Fructobacillus fructosus | 2323 | Copenhagen | Rosa |
| 12 | Fructobacillus fructosus | 2321 | Copenhagen | Geranium |
| 13 | Fructobacillus fructosus | 2361 | Silkeborg | Rubus |
| 14 | Fructobacillus fructosus | 2347 | Copenhagen | Rosa |
| 15 | Fructobacillus fructosus | 2325 | Copenhagen | Rubus |
| 16 | Fructobacillus fructosus | 2319 | Copenhagen | Syringa |
| 17 | Fructobacillus fructosus | 2376 | Odense | Convolvulus |
| 18 | Fructobacillus fructosus | 2393 | Silkeborg | Lavandula |
| 19 | Fructobacillus pseudoficulneus | 2222 | Aarhus | Betonica |
| 20 | Fructobacillus tropaeoli | 2365 | Silkeborg | Lavandula |
| 21 | Levilactobacillus brevis | 2055 | Aarhus | Eschscholzia |
| 22 | Lactiplantibacillus paraplantarum | 2184 | Odense | Cirsium |
| 23 | Lactiplantibacillus pentosus | 2185 | Odense | Cirsium |
| 24 | Lactiplantibacillus plantarum | 2183 | Odense | Cirsium |
| 25 | Latilactobacillus sakei | 2317 | Copenhagen | Stellaria |
| 26 | Lactococcus garvieae | 2331 | Copenhagen | Hyacinthus |
| 27 | Lactococcus lactis | 2358 | Aarhus | Erythranthe |
| 28 | Lactococcus lactis | 2332 | Copenhagen | Hyacinthus |
| 29 | Lactococcus lactis | 2336 | Copenhagen | Trifolium |
| 30 | Leuconostoc mesenteroides | 2012 | Copenhagen | Forsythia |
| 31 | Leuconostoc mesenteroides | 2011 | Copenhagen | Prunus |
| 32 | Leuconostoc mesenteroides | 2008 | Copenhagen | Aubrieta |
| 33 | Leuconostoc mesenteroides | 2181 | Aarhus | Telekia |
| 34 | Leuconostoc mesenteroides | 2333 | Copenhagen | Prunus |
| 35 | Leuconostoc mesenteroides | 2343 | Copenhagen | Trifolium |
| 36 | Leuconostoc mesenteroides | 2329 | Copenhagen | Ranunculus |
| 37 | Leuconostoc mesenteroides | 2327 | Copenhagen | Hottonia |
| 38 | Leuconostoc mesenteroides | 2334 | Copenhagen | Trifolium |
| 39 | Leuconostoc mesenteroides | 2350 | Copenhagen | Bellis |
| 40 | Leuconostoc mesenteroides | 2182 | Aarhus | Telekia |
| 41 | Leuconostoc mesenteroides | 2377 | Aarhus | Campanula |
| 42 | Leuconostoc miyukkimchii | 2224 | Copenhagen | Rosa |
| 43 | Leuconostoc sp. | 2228 | Aarhus | Dasiphora |
| 44 | Leuconostoc sp. | 2378 | Aarhus | Black mullein |
| 45 | Leuconostoc sp. THK-X10 | 2246 | Copenhagen | Rosa |
| 46 | Pediococcus acidilactici | 2053 | Aarhus | Betonica |
| 47 | Pediococcus acidilactici | 2057 | Aarhus | Fuchsia |
| 48 | Pediococcus acidilactici | 2357 | Aarhus | Erythranthe |
| 49 | Pediococcus pentosaceus | 2051 | Aarhus | Hydrangea |
| 50 | Pediococcus pentosaceus | 2048 | Aarhus | Dasiphora |
| 51 | Pediococcus pentosaceus | 2379 | Aarhus | Teucrium |
| 52 | Pediococcus pentosaceus | 2369 | Odense | Artemisia |
| 53 | Weissella bombi | 2356 | Aarhus | Erythranthe |
| 54 | Weissella bombi | 2346 | Aarhus | Teucrium |
| 55 | Weissella bombi | 2371 | Odense | Agastache |
| 56 | Weissella minor | 2054 | Aarhus | Betonica |
| 57 | Weissella paramesenteroides | 2341 | Copenhagen | Trifolium |
| 58 | Weissella thailandensis | 2056 | Odense | Convolvulus |
| 59 | Weissella thailandensis | 2364 | Silkeborg | Lavandula |
| 60 | Weissella viridescens | 2320 | Copenhagen | Cardamine |
| 61 | Weissella viridescens | 2318 | Copenhagen | Cotoneaster |
| NFICC Codes | Species | 2% Sucrose | 2% Sucrose and 1% Glucose | ||
|---|---|---|---|---|---|
| Slimy | Ropy | Slimy | Ropy | ||
| 2324 | Apilactobacillus kunkeei | − | + | + | + |
| 2362 | Apilactobacillus kunkeei | + | + | ++ | − |
| 2370 | Apilactobacillus ozensis | ++ | + | − | + |
| 2374 | Apilactobacillus ozensis | +++ | − | ++ | − |
| 2363 | Apilactobacillus ozensis | − | + | − | + |
| 2366 | Apilactobacillus ozensis | − | +++ | − | ++ |
| 2347 | Fructobacillus fructosus | + | − | − | + |
| 2185 | Lactobacillus pentosus | +− | − | − | − |
| 2183 | Lactiplantibacillus plantarum | +− | − | − | − |
| 2331 | Lactococcus garvieae | +− | + | +− | + |
| 2336 | Lactococcus lactis | + | ++ | ++ | + |
| 2012 | Leuconostoc mesenteroides | − | + | ++ | +− |
| 2011 | Leuconostoc mesenteroides | +− | +− | +− | + |
| 2008 | Leuconostoc mesenteroides | − | + | + | + |
| 2181 | Leuconostoc mesenteroides | +− | − | ++ | − |
| 2333 | Leuconostoc mesenteroides | + | + | ++ | + |
| 2329 | Leuconostoc mesenteroides | + | − | + | − |
| 2327 | Leuconostoc mesenteroides | + | − | + | − |
| 2334 | Leuconostoc mesenteroides | +− | − | + | − |
| 2350 | Leuconostoc mesenteroides | − | +− | − | − |
| 2182 | Leuconostoc mesenteroides | + | − | ++ | − |
| 2224 | Leuconostoc miyukkimchii | − | + | + | ++ |
| 2228 | Leuconostoc sp. | + | + | + | + |
| 2246 | Leuconostoc sp. THK-X10 | + | − | + | + |
| 2057 | Pediococcus acidilactici | − | +++ | − | +++ |
| 2051 | Pediococcus pentosaceus | + | − | − | − |
| 2048 | Pediococcus pentosaceus | + | + | − | − |
| 2369 | Pediococcus pentosaceus | − | +++ | − | +++ |
| 2379 | Pediococcus pentosaceus | − | + | − | + |
| 2371 | Weissella bombi | ++ | − | ++ | − |
| 2054 | Weissella minor | + | + | ++ | + |
| 2341 | Weissella paramesenteroides | + | + | + | + |
| 2056 | Weissella thailandensis | + | − | ++ | − |
| 2318 | Weissella viridescens | + | − | − | +− |
| 2393 | Fructobacillus fructosus | + | − | − | − |
| 2378 | Leuconostoc sp. | + | − | ++ | + |
| 2377 | Leuconostoc mesenteroides | + | − | + | + |
| 2412 | Apilactobacillus sp. | + | − | − | − |
| 2365 | Fructobacillus tropaeoli | + | − | − | − |
| 2364 | Weissella thailandensis | + | − | − | ++ |
Disclaimer/Publisher’s Note: The statements, opinions and data contained in all publications are solely those of the individual author(s) and contributor(s) and not of MDPI and/or the editor(s). MDPI and/or the editor(s) disclaim responsibility for any injury to people or property resulting from any ideas, methods, instructions or products referred to in the content. |
© 2024 by the authors. Licensee MDPI, Basel, Switzerland. This article is an open access article distributed under the terms and conditions of the Creative Commons Attribution (CC BY) license (https://creativecommons.org/licenses/by/4.0/).
Share and Cite
Khiabani, A.; Xiao, H.; Wätjen, A.P.; Tovar, M.; Poulsen, V.K.; Hansen, E.B.; Bang-Berthelsen, C.H. Exploring the Diversity and Potential Use of Flower-Derived Lactic Acid Bacteria in Plant-Based Fermentation: Insights into Exo-Cellular Polysaccharide Production. Foods 2024, 13, 2907. https://doi.org/10.3390/foods13182907
Khiabani A, Xiao H, Wätjen AP, Tovar M, Poulsen VK, Hansen EB, Bang-Berthelsen CH. Exploring the Diversity and Potential Use of Flower-Derived Lactic Acid Bacteria in Plant-Based Fermentation: Insights into Exo-Cellular Polysaccharide Production. Foods. 2024; 13(18):2907. https://doi.org/10.3390/foods13182907
Chicago/Turabian StyleKhiabani, Azadeh, Hang Xiao, Anders Peter Wätjen, Miguel Tovar, Vera Kuzina Poulsen, Egon Bech Hansen, and Claus Heiner Bang-Berthelsen. 2024. "Exploring the Diversity and Potential Use of Flower-Derived Lactic Acid Bacteria in Plant-Based Fermentation: Insights into Exo-Cellular Polysaccharide Production" Foods 13, no. 18: 2907. https://doi.org/10.3390/foods13182907
APA StyleKhiabani, A., Xiao, H., Wätjen, A. P., Tovar, M., Poulsen, V. K., Hansen, E. B., & Bang-Berthelsen, C. H. (2024). Exploring the Diversity and Potential Use of Flower-Derived Lactic Acid Bacteria in Plant-Based Fermentation: Insights into Exo-Cellular Polysaccharide Production. Foods, 13(18), 2907. https://doi.org/10.3390/foods13182907

